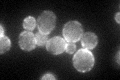
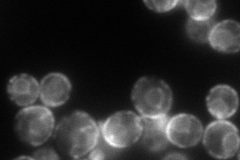
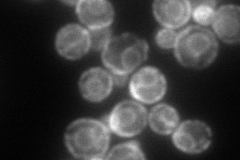
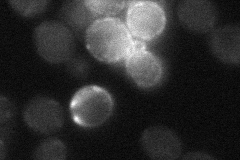
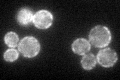

View description
Lipid-binding protein containing three calcium and lipid binding domains; non-tagged protein localizes to mitochondria and GFP-fusion protein localizes to the cell periphery; C-termini of Tcb1p, Tcb2p and Tcb3p interact
Localization:
Intensity:
Fold change:
Significance:
-
C’ GFP library in SD
cell periphery55.81 -
N' NOP1pr-GFP in SD
ER140.586 -
N' TEF2pr-mCherry in SD
cell periphery,ER129.929 -
N' NATIVEpr-GFP in SD
cell periphery,punctate22.2617 -
N' TEF2pr-VC and Cyto-VN in SD

ER48.5938 -
C’ GFP library in SD+DTT

cell periphery69.371.24No -
C’ GFP library in SD+H2O2

cell periphery64.831.16No -
C’ GFP library in Starvation Media
cell periphery93.521.67Yes -
C’ GFP library on the background of Pup2-DaMP

cell periphery -
C’ GFP library on the background of CCT mutant

cell periphery71.61221.283No
